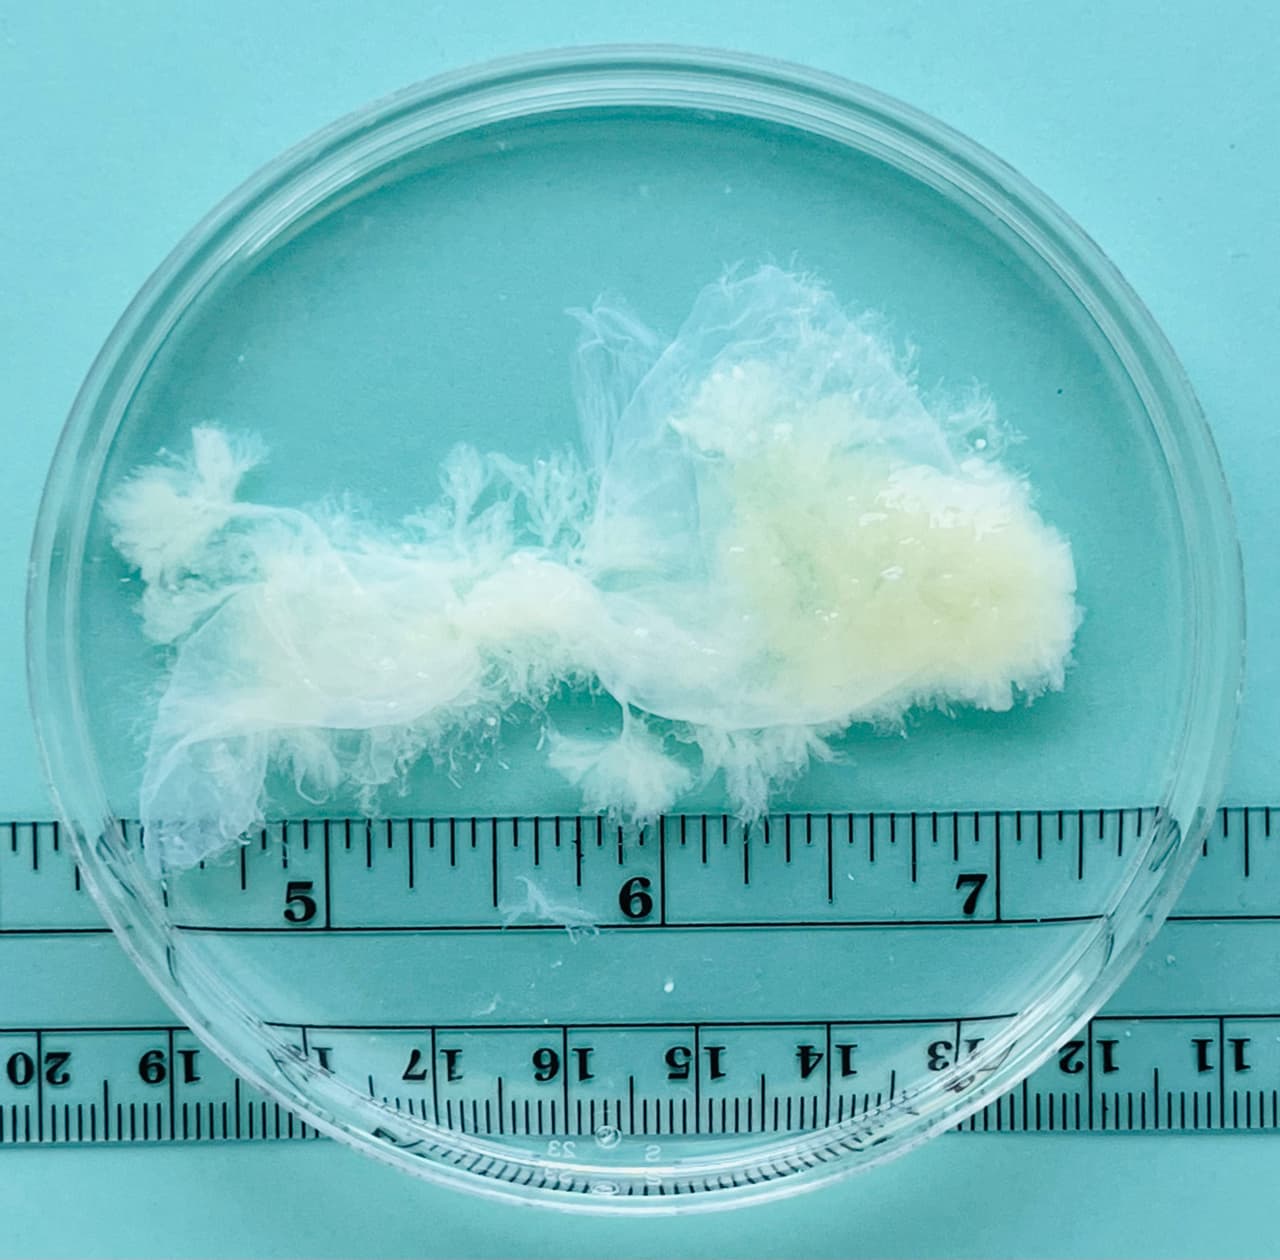
<b>Semana 9 del embarazo.</b> Alrededor del 85% de todos los abortos en los EEUU ocurren antes de las 9 semanas de embarazo, señala MYA. "Nuestro objetivo es contrarrestar la información errónea con hechos sobre cómo se ve el tejido del embarazo en un aborto temprano o espontáneo", dice la red en su 
<a href="https://myanetwork.org/the-issue-of-tissue/" target="_blank">página web</a>.

La Corte Suprema extendió el viernes la suspensión de un fallo de un tribunal inferior que había impuesto r estricciones al acceso a un medicamento abortivo, una medida temporal destinada a dar a los jueces más tiempo para considerar el tema.
Corte Suprema suspende el fallo que limita el acceso a la píldora abortiva mifepristona
La medida no refleja la disposición final del caso y solo busca darle tiempo a los jueces para considerar una apelación de emergencia presentada por el Departamento de Justicia y la compañía farmaceútica Danco, uno de los fabricantes.
La decisión del magistrado Samuel Alito suspendió el fallo del tribunal inferior hasta las 11:59 pm hora del este del miércoles y pidió una respuesta de los demandantes para el martes al mediodía.
Notas Relacionadas
El caso contra la píldora abortiva mifepristona
La semana pasada el juez Matthew Kacsmaryk del Tribunal Federal del Distrito Norte de Texas, quien fue nominado al cargo por el expresidente Donald Trump, anuló la aprobación por parte de Administración de Alimentos y Medicamentos (FDA en inglés) de la venta de la píldora abortiva mifepristona, una de las drogas más usadas para terminar un embarazo en lugar de cirugía.
El miércoles la Corte Federal de Apelaciones del Quinto Circuito congeló parte del fallo de Kacsmaryk, permitiendo que la píldora permanezca en el mercado, pero bajo importantes limitaciones.
Entre dichas limitaciones se encuentra la imposibilidad de enviar la píldora por correo a los pacientes que la obtuvieron a través de consultas de telesalud y los obliga a viajar a un hospital para obtener el medicamento en persona, similar a lo que ocurría antes de 2016.
Las limitaciones también acortan el periodo para obtener la píldora a siete semanas de embarazo en lugar de las 10 semanas permitidas actualmente.
Expertos indican que el mantenimiento del fallo de la corte de apelación constituiría la limitación al acceso al aborto más importante desde que la Corte Suprema anuló la protección federal al aborto en junio pasado, en una decisión que también fue escrita por el juez Alito.
La mifepristona es el medicamento que se usa en la mayoría de los abortos actualmente en los estados que aún permiten llevar a cabo el procedimiento.
Los alegatos del Departamento de Justicia contra los fallos de las cortes inferiores
El Departamento de Justicia alega que los fallos del tribunal federal de distrito y el tribunal federal de apelaciones son “órdenes judiciales inferiores sin precedentes que anulan el juicio científico de la FDA y desatan el caos regulatorio al suspender las condiciones de uso existentes aprobadas por la FDA para la mifepristona”.
El departamento dijo además en su presentación que de mantenerse las limitaciones se “infligiría un daño grave a las mujeres, el sistema médico, la agencia y el público”.
“La FDA ha mantenido ese criterio científico en cinco administraciones presidenciales y ha modificado las condiciones originales de aprobación de la mifepristona, ya que décadas de experiencia han demostrado de manera concluyente la seguridad del fármaco”, dijo la presentación del Departamento de Justicia, recordando que “más de la mitad de las mujeres en este país que optan por interrumpir sus embarazos confían en la mifepristona para hacerlo”.
El departamento cuestionó además la legitimidad de los demandantes originales para buscar la nulidad de la aprobación de la FDA. Dichos demandantes son un grupo de médicos antiaborto que según el departamento no toman ni prescriben el medicamento, y la aprobación de la FDA “no les obliga a hacer o abstenerse de hacer nada”.
La FDA aprobó la mifepristona después de un proceso de revisión de la píldora que duró cuatro años.
El Departamento de Justicia indicó que en los 23 años desde que se aprobó el uso de la mifepristona, la píldora ha demostrado ser una forma segura y efectiva de interrumpir un embarazo, pero aún así los demandantes alegaron que la FDA violó la ley al no tener en cuenta los supuestos riesgos.